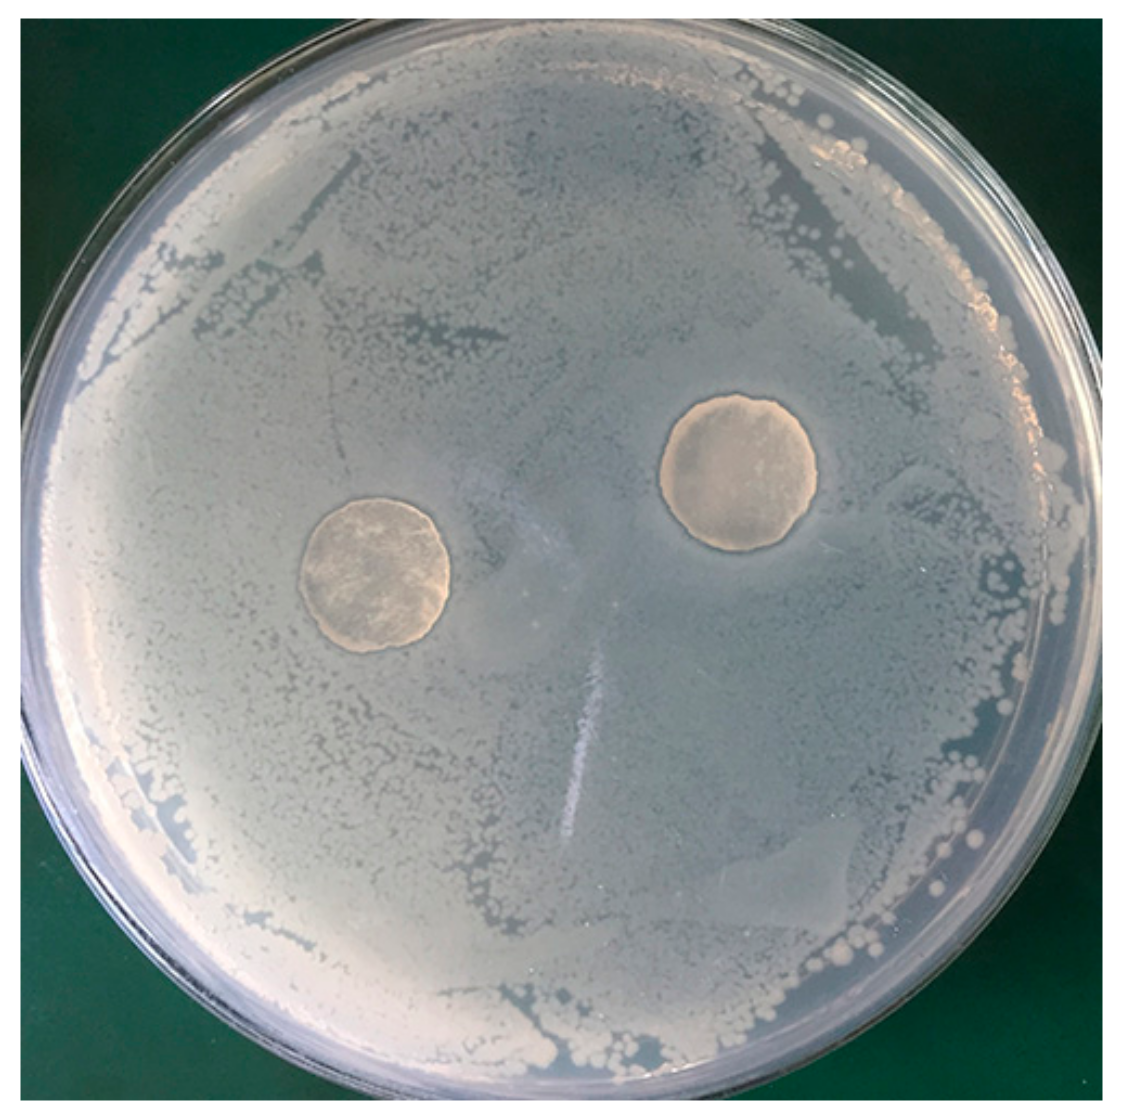
Polymers 11 01846 g005

Green-Based Antimicrobial Hydrogels Prepared from Bagasse Cellulose as 3D-Scaffolds for Wound Dressing
Abstract
1. Introduction
2. Materials and Methods
2.1. Materials
2.2. Synthesis of Cellulose Grafted with Polyhexamethylene Guanidine Hydrochloride
2.3. Hydrogel Preparation
2.4. Polymer and Hydrogel Characterization
2.5. Compression Test
2.6. Swelling Characterization
2.7. Testing of Antimicrobial Activity
2.8. Cell Viability
3. Results and Discussion
3.1. Hydrogel Characterizations
3.1.1. Antimicrobial Modification of Cellulose with PHGH
3.1.2. Chemical Interactions of Functional Groups in Hydrogel
3.1.3. FTIR of Cellulose and Hydrogel
3.1.4. SEM Analysis
3.2. Swelling Properties
3.3. Mechanical Properties
3.4. Antibacterial Activity of P-SBC and P-CH
3.5. Cytotoxic Characterization of P-CH Dressing
4. Conclusions
Author Contributions
Funding
Conflicts of Interest
References
- Boer, M.; Duchnik, E.; Maleszka, R.; Marchlewicz, M. Structural and biophysical characteristics of human skin in maintaining proper epidermal barrier function. Adv. Dermatol. Allergol. 2016, 33, 1–5. [Google Scholar] [CrossRef] [PubMed]
- Sun, B.K.; Zurab, S.; Khavari, P.A. Advances in skin grafting and treatment of cutaneous wounds. Science 2014, 346, 941–945. [Google Scholar] [CrossRef] [PubMed]
- Ma, Y.; Xin, L.; Tan, H.; Fan, M.; Li, J.; Jia, Y.; Ling, Z.; Chen, Y.; Hu, X. Chitosan membrane dressings toughened by glycerol to load antibacterial drugs for wound healing. Mater. Sci. Eng. C 2017, 81, 522–531. [Google Scholar] [CrossRef] [PubMed]
- Xie, H.; Chen, X.; Shen, X.; He, Y.; Chen, W.; Luo, Q.; Ge, W.; Yuan, W.; Tang, X.; Hou, D. Preparation of chitosan-collagen-alginate composite dressing and its promoting effects on wound healing. Int. J. Biol. Macromol. 2017, 107, 93–104. [Google Scholar] [CrossRef] [PubMed]
- Castangia, I.; Nácher, A.; Caddeo, C.; Valenti, D.; Fadda, A.M.; Díez-Sales, O.; Ruiz-Saurí, A.; Manconi, M. Fabrication of quercetin and curcumin bionanovesicles for the prevention and rapid regeneration of full-thickness skin defects on mice. Acta Biomater. 2014, 10, 1292–1300. [Google Scholar] [CrossRef] [PubMed]
- Gong, C.Y.; Wu, Q.J.; Wang, Y.J.; Zhang, D.D.; Luo, F.; Zhao, X.; Wei, Y.Q.; Qian, Z.Y. A biodegradable hydrogel system containing curcumin encapsulated in micelles for cutaneous wound healing. Biomaterials 2013, 34, 6377–6387. [Google Scholar] [CrossRef] [PubMed]
- Jin, S.G.; Kim, K.S.; Kim, D.W.; Kim, D.S.; Seo, Y.G.; Go, T.G.; Youn, Y.S.; Kim, J.O.; Yong, C.S.; Choi, H.G. Development of a novel sodium fusidate-loaded triple polymer hydrogel wound dressing: Mechanical properties and effects on wound repair. Int. J. Pharm. 2016, 497, 114–122. [Google Scholar] [CrossRef] [PubMed]
- Simões, D.; Miguel, S.P.; Ribeiro, M.P.; Coutinho, P.; Mendonça, A.G.; Correia, I.J. Recent advances on antimicrobial wound dressing: A review. Eur. J. Pharm. Biopharm. 2018, 127, 130–141. [Google Scholar] [CrossRef] [PubMed]
- Naseri-Nosar, M.; Ziora, Z.M. Wound dressings from naturally-occurring polymers: A review on homopolysaccharide-based composites. Carbohydr. Polym. 2018, 189, 379–398. [Google Scholar] [CrossRef] [PubMed]
- Ahmed, E.M. Hydrogel: Preparation, characterization, and applications: A review. J. Adv. Res. 2015, 6, 105–121. [Google Scholar] [CrossRef] [PubMed]
- Chang, C.; Bo, D.; Jie, C.; Zhang, L. Superabsorbent hydrogels based on cellulose for smart swelling and controllable delivery. Eur. Polym. J. 2010, 46, 92–100. [Google Scholar] [CrossRef]
- Jing Xie, J; Li, J. Smart drug delivery system based on nanocelluloses. J Bioresour. Bioprod. 2017, 2, 1–3. [Google Scholar]
- Carvalho, I.C.; Mansur, H.S. Engineered 3D-scaffolds of photocrosslinked chitosan-gelatin hydrogel hybrids for chronic wound dressings and regeneration. Mater. Sci. Eng. C 2017, 78, 690–705. [Google Scholar] [CrossRef] [PubMed]
- Aldana, A.A.; Abraham, G.A. Current advances in electrospun gelatin-based scaffolds for tissue engineering applications. Int. J. Pharm. 2017, 523, 441–453. [Google Scholar] [CrossRef] [PubMed]
- Zhao, X.; Wu, H.; Guo, B.; Dong, R.; Qiu, Y.; Ma, P.X. Antibacterial anti-oxidant electroactive injectable hydrogel as self-healing wound dressing with hemostasis and adhesiveness for cutaneous wound healing. Biomaterials 2017, 122, 34–47. [Google Scholar] [CrossRef] [PubMed]
- Chang, C.; Zhang, L. Cellulose-based hydrogels: Present status and application prospects. Carbohydr. Polym. 2011, 84, 40–53. [Google Scholar] [CrossRef]
- Hernandez-Rangel, A.; Silva-Bermudez, P.; Espana-Sanchez, B.L.; Luna-Hernandez, E.; Almaguer-Flores, A.; Ibarra, C.; Garcia-Perez, V.I.; Velasquillo, C.; Luna-Barcenas, G. Fabrication and in vitro behavior of dual-function chitosan/silver nanocomposites for potential wound dressing applications. Mater. Sci. Eng. C 2019, 94, 750–765. [Google Scholar] [CrossRef] [PubMed]
- Ma, L. Collagen/chitosan porous scaffolds with improved biostability for skin tissue engineering. Biomaterials 2003, 24, 4833–4841. [Google Scholar] [CrossRef]
- Zhang, H.; Peng, M.; Cheng, T.; Peng, Z.; Qiu, L.; Zhou, J.; Lu, G.; Chen, J. Silver nanoparticles-doped collagen–alginate antimicrobial biocomposite as potential wound dressing. J. Mater. Sci. 2018, 53, 14944–14952. [Google Scholar] [CrossRef]
- Zmejkoski, D.; Spasojević, D.; Orlovska, I.; Kozyrovska, N.; Soković, M.; Glamočlija, J.; Dmitrović, S.; Matović, B.; Tasić, N.; Maksimović, V. Bacterial cellulose-lignin composite hydrogel as a promising agent in chronic wound healing. Int. J. Biol. Macromol. 2018, 118, 494–503. [Google Scholar] [CrossRef] [PubMed]
- Pasqui, D.; Torricelli, P.; Cagna, M.D.; Fini, M.; Barbucci, R. Carboxymethyl cellulose—hydroxyapatite hybrid hydrogel as a composite material for bone tissue engineering applications. J. Biomed. Mater. Res. A 2014, 102, 1568–1579. [Google Scholar] [CrossRef] [PubMed]
- Shah, S.A.; Sohail, M.; Khan, S.; Minhas, M.U.; Matas, M.; Sikstone, V.; Hussain, Z.; Abbasi, M.; Kousar, M. Biopolymer-based biomaterials for accelerated diabetic wound healing: A critical review. Int. J. Biol. Macromol. 2019, 139, 975–993. [Google Scholar] [CrossRef] [PubMed]
- Pan, Y.; Xiao, H.; Cai, P.; Colpitts, M. Cellulose fibers modified with nano-sized antimicrobial polymer latex for pathogen deactivation. Carbohyd. Polym. 2016, 135, 94–100. [Google Scholar] [CrossRef] [PubMed]
- Ng, V.W.L.; Chan, J.M.W.; Sardon, H.; Ono, R.J.; García, J.M.; Yi, Y.Y.; Hedrick, J.L. Antimicrobial hydrogels: A new weapon in the arsenal against multidrug-resistant infections. Adv. Drug Deliv. Rev. 2014, 78, 46–62. [Google Scholar] [CrossRef] [PubMed]
- Qiu, X.; Hu, S. “Smart” materials based on cellulose: A review of the preparations, properties, and applications. Materials 2013, 6, 738–781. [Google Scholar] [CrossRef] [PubMed]
- Shen, X.; Shamshina, J.L.; Berton, P.; Gurau, G.; Rogers, R.D. Hydrogels based on cellulose and chitin: fabrication, properties, and applications. Green Chem. 2016, 18, 53–75. [Google Scholar] [CrossRef]
- Fan, Z.; Liu, B.; Wang, J.; Zhang, S.; Lin, Q.; Gong, P.; Ma, L.; Yang, S. A novel wound dressing based on Ag/graphene polymer hydrogel: Effectively kill bacteria and accelerate wound healing. Adv. Funct. Mater. 2014, 24, 3933–3943. [Google Scholar] [CrossRef]
- Guan, Y.; Xiao, H.; Sullivan, H.; Zheng, A. Antimicrobial-modified sulfite pulps prepared by in situ copolymerization. Carbohydr. Polym. 2007, 69, 688–696. [Google Scholar] [CrossRef]
- Bailey, J.K.; Sammet, S.; Overocker, J.; Craft-Coffman, B.; Acevedo, C.M.; Cowan, M.E.; Powell, H.M. MRI compatibility of silver based wound dressings. Burns 2018, 44, 1940–1946. [Google Scholar] [CrossRef] [PubMed]
- Pan, Y.; Xia, Q.; Xiao, H. Cationic polymers with tailored structures for rendering polysaccharide-based materials. Polymers 2019, 11, 1283. [Google Scholar] [CrossRef] [PubMed]
- Kumar, R.; Sharma, R.K.; Singh, A.P. Grafted cellulose: A bio-based polymer for durable applications. Polym. Bull. 2018, 75, 2213–2242. [Google Scholar] [CrossRef]
- Wei, D.F; Ma, Q.X.; Guan, Y.; Hu, F.Z.; Zheng, A.N.; Zhang, X.; Teng, Z.; Jiang, H. Structural characterization and antibacterial activity of oligoguanidine (polyhexamethylene guanidine hydrochloride). Mater. Sci. Eng. C 2009, 29, 1776–1780. [Google Scholar] [CrossRef]
- Wang, F.; Pan, Y.; Cai, P.; Guo, T.; Xiao, H. Single and binary adsorption of heavy metal ions from aqueous solutions using sugarcane cellulose-based adsorbent. Bioresour. Technol. 2017, 241, 482–490. [Google Scholar] [CrossRef] [PubMed]
- Pan, Y.; Wang, J.; Cai, P.; Xiao, H. Dual-responsive IPN hydrogel based on sugarcane bagasse cellulose as drug carrier. Int. J. Biol. Macromol. 2018, 118, 132–140. [Google Scholar] [CrossRef] [PubMed]
- Wei, D.; Li, Z.; Wang, H.; Liu, J.; Xiao, H.; Zheng, A.; Guan, Y. Antimicrobial paper obtained by dip-coating with modified guanidine-based particle aqueous dispersion. Cellulose 2017, 24, 3901–3910. [Google Scholar] [CrossRef]
- Qian, L.; Xiao, H.; Zhao, G.; He, B. Synthesis of modified guanidine-based polymers and their antimicrobial activities revealed by AFM and CLSM. ACS Appl. Mater. Interfaces 2011, 3, 1895–1901. [Google Scholar] [CrossRef] [PubMed]
- Li, Y.; Cai, P.; Tong, Z.-f.; Xiao, H.; Pan, Y. Preparation of Copolymer-Based Nanoparticles with Broad-Spectrum Antimicrobial Activity. Polymers 2017, 9, 717. [Google Scholar] [CrossRef] [PubMed]

| Samples | PHGH Contents (wt %) | Growth Inhibition of Cells After 24 h Incubation (%) |
|---|---|---|
| Control | 0.0 | - |
| 0.5 | >99.99 | |
| P-SBC | 1.0 | >99.99 |
| 1.5 | >99.99 | |
| P-CH | 1.0 | 97.60 |
| 1.5 | >99.99 |
© 2019 by the authors. Licensee MDPI, Basel, Switzerland. This article is an open access article distributed under the terms and conditions of the Creative Commons Attribution (CC BY) license (http://creativecommons.org/licenses/by/4.0/).
Share and Cite
Pan, Y.; Zhao, X.; Li, X.; Cai, P. Green-Based Antimicrobial Hydrogels Prepared from Bagasse Cellulose as 3D-Scaffolds for Wound Dressing. Polymers 2019, 11, 1846. https://doi.org/10.3390/polym11111846
Pan Y, Zhao X, Li X, Cai P. Green-Based Antimicrobial Hydrogels Prepared from Bagasse Cellulose as 3D-Scaffolds for Wound Dressing. Polymers. 2019; 11(11):1846. https://doi.org/10.3390/polym11111846
Chicago/Turabian StylePan, Yuanfeng, Xiao Zhao, Xiaoning Li, and Pingxiong Cai. 2019. "Green-Based Antimicrobial Hydrogels Prepared from Bagasse Cellulose as 3D-Scaffolds for Wound Dressing" Polymers 11, no. 11: 1846. https://doi.org/10.3390/polym11111846
APA StylePan, Y., Zhao, X., Li, X., & Cai, P. (2019). Green-Based Antimicrobial Hydrogels Prepared from Bagasse Cellulose as 3D-Scaffolds for Wound Dressing. Polymers, 11(11), 1846. https://doi.org/10.3390/polym11111846





